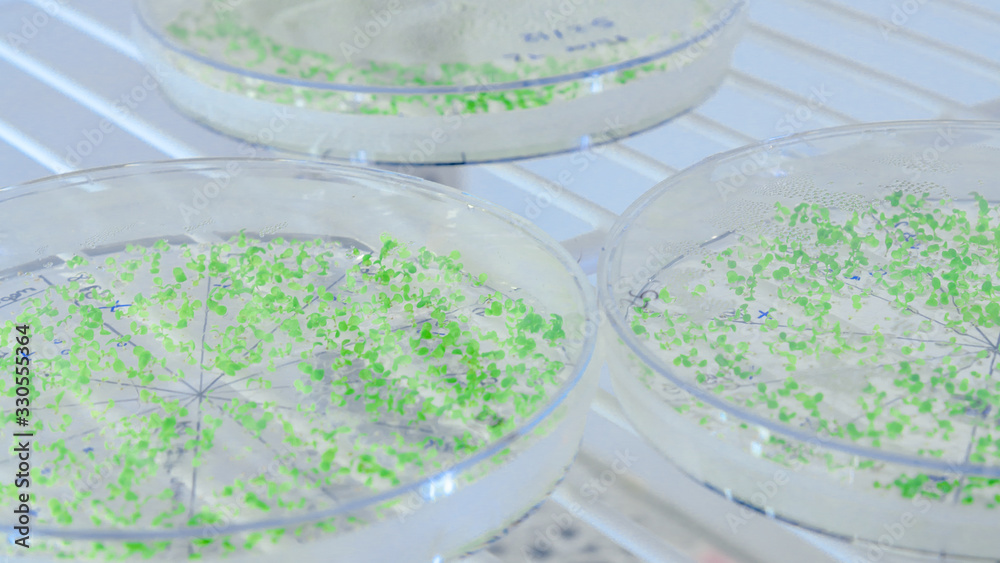

Keine Artikel
Preise inkl. MwSt.
Se ha añadido un nuevo artículo a tu cesta.
¡Buen Trabajo!
Se ha añadido un nuevo artículo a tu cesta.
Artículos en su carrito. 1 Artículo en su carrito.
Close-up of cultures in petri dishes in bioscience laboratory refrigerator. Concept of science, laboratory and study of diseases. #330555364

Más informacion
¿Cómo personalizar el fotomural para pared?
¿Qué imagen quieres?
Los fotomurales de pared permiten una personalización completa. Puedes tanto escoger un imagen tuya como cualquiera de las que te ofrecemos en nuestro banco de imágenes.
¿Tienes claras las medidas?
Puedes diseñar tu fotomural para pared como desees. A partir de los 30cm de alto y ancho, hasta los 5000cm.
Las características del material
Se trata de un vinilo fotomural polimérico con una gran calidad. Este material es rígido y está impreso con tecnología uvi; por lo que no necesita ser laminado.
¿Qué efecto buscas?
Los efectos que puedes aplicarle a tus fotomurales en pared personalizados son:
Sin efecto.
Blanco y negro.
Sepia.
Frío.
Flip horizontal.
Flip vertical.
Rotar.
Ventajas de los fotomurales de pared
Fácil instalación (110 micras).
Permiten decorar grandes espacios.
Disimula las imperfecciones. Sus acabados en mate permiten que las imperfecciones en la pared se disimulen.
Gran capacidad de personalización. Puedes elegir cómo estructural tu fotomural, así como las fotos que quieres obtener en tu diseño.
¿Cómo colocar el fotomural pared?
Saber colocar el fotomural pared es realmente sencillo. Con tu pedido te entregamos todos lo que necesitas para colocar el adhesivo de la mejor manera, y así conseguir los mejores resultados.
Los fotomurales son una opción ideal para todo tipo de espacios: puedes colocarlo tanto en cualquier lugar de la casa como en tu negocio.
Mas materiales para cuadros personalizados



















